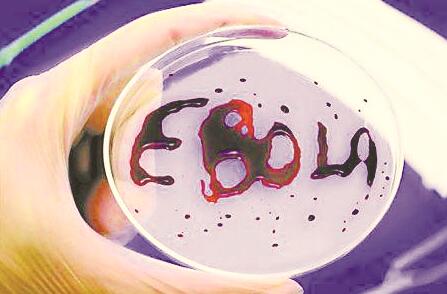
1544003334227552.jpg 2.jpg

易道医学研究会李会长研究发现,冷空气是埃博拉病毒的煞星,是天然的疫苗,不仅结束了今年5月刚果(金)的埃博拉疫情,而且今后非洲的埃博拉病毒再也不那么可怕,中医药治疗可有效降低埃博拉死亡率,埃博拉疫情将不会再大规模爆发。
2018年5月23日,刚果(金)爆发埃博拉疫情,刚果(金)总统的中国顾问姚会长向广州中医药大学基础学院贺振泉院长求助,贺院长将《伤寒经方治疗时令瘟疫的心悟》这篇文章转发给姚会长,6月12日便彻底结束疫情。治疗埃博拉关键是离开高温环境,这一次的疫情刚果(金)方面没有向中医求援。

解析“埃博拉病毒病”爆发的主要缘由
埃博拉病毒病是怎么来的?世卫组织认为黑猩猩将病毒传染给人类,造成埃博拉出血热病,死亡率达50%,但中医有不同的判断。先来剖析去年的疫情通报,2017年5月12日,刚果(金)卫生部宣布北部不苇莱省自4月22日以来,发现9例埃博拉出血热疑似病例,其中两人已死亡,送检血液样本中,有1例确认为埃博拉病阳性,刚果卫生部称已通报世界卫生组织请求帮助。为什么会出现一例确认? 因为这例血液样本是从尸体中抽出来的,经过21天的高烧不退之后,这具全身化脓的尸体在高温环境下,没有做任何消毒处理,停尸家中,待亲友前来告别时,产生埃博拉病毒,而另外一具尸体,由于得到及时处理,所以没有产生病毒,9例疑似患者,其中7例治疗后退烧康复,一具尸体阴性,一具尸体阳性,这具阳性尸体是2017年的第一例埃博垃,病毒是高温停尸期间产生的,与黑猩猩无关,如果是黑猩猩传染人类,不会只有一例。9例疑似者都必然是阳性。
假设2017年这第一例埃博拉尸体处理不当,亲友仍然与尸体在高温中吻别,都感染了病毒,导致埃博拉病爆发,这时所有亲友都是病毒阳性。因为病毒是从人的尸体产生的,所以这种病毒会通过呼吸传播,人传人,令人突发高烧,爆发疫情,但感染了病毒,并不是马上就发高烧,身体有口腔炎、咽喉炎、肺炎的患者会在一两天内发病,身体健康强壮的人迟一些发病,少数人不发病,这群感染病毒的亲友,在吻别之后,立即煎中药汤服食,可有效预防埃博拉病发,火神卢氏第三代传人卢崇汉先生,在2008年“5·12”汶川地震时,公布了一条预防瘟疫的药方:
桂枝尖15克、苍术15 克、法半夏20克、白芷15克、广藿香15克、石昌蒲20克、陈皮15克、白寇12克 、茯苓15克、 炙甘草5克 、生姜20克,水煎,一日分三次服用。
当年参加抗震救灾的战士,许多人出现了有恶心、呕吐、吃不下饭的症状,服食这个中药汤后,迅速康复,是经过实战检验的防治瘟疫的良方,有病治病,无病预防,适合男女老少(小孩药量减半)。每天一剂,连服五剂。
埃博拉病要在30摄氏度及以上才凶险无比,患者在高温中很难退烧,拖延到12天后,开始皮肤溃烂出血,是因为退不了烧才出血,并不是感染病毒出血发高烧,由于错误的防治方法,将患者拖延到21天高烧不退,才导致五脏出血死亡的。
下面是我在2017巴厘岛世界传统医学大会的英语演讲:“埃博拉发病症状主要是高烧无 汗、恶心、呕吐、全身酸痛、后期皮肤出血、溃烂化脓而死,为什么后期出血溃烂?是因为吃平常的退烧药无效,十几天持续高烧造成出血的,中医认为埃博拉就是时令瘟疫,与非洲地区的气候、地理有关,所有活的动物都不会产生病毒,但动物的尸体会产生病毒,包括人类的尸体(病毒从尸体中产生,在特殊的气候下造成时令瘟疫,冬天是禽流感, 从白鸽、鸡等活禽上检测到病毒,这些蛋生的羽毛动物尸体,产生的病毒不会人传人,夏天的埃博拉,从黑猩猩、骆驼上检测到病毒,这些胎生的毛动物,尸体产生的病毒会人传人),埃博拉病毒就是人的尸体产生的,分析埃博拉疫情,历年的疫区都在紫外线较强的非洲赤道上,夏天酷热,地表温度中午达50摄氏度,气压强度增大,这时人体发烧,吃平常的退烧药无法出汗散热,患者在持续高热12天后,开始皮肤溃烂出血化脓,通常在高烧20天内死亡,且这些地区都贫穷落后,当地习俗将尸体停放家中,让亲友前来吻别(没有做任何防腐消毒处理),尸体在高温中产生埃博拉病毒,通过吻别爆发。”
2018 年5月23日,刚果(金)卫生部通报,随着4人新增确认病例,本轮埃博拉疫情已确诊21人,疫区死亡人数升至26人,其中一个小山村死亡17人,另外,还有21人被诊断“很可能”感染埃博拉病毒。5月24日,广州中医药大学贺振泉院长打电话给我,说刚果(金)爆发埃博拉疫情,他的朋友姚会长是刚果(金)总统的顾问,请贺院长组织中医团队前去治疗,问我参不参加,我马上报名,并且当天发了护照的照片给贺院长。因为2015年7月贺院长组织民间中医座谈,我在发言时,说出登革热与蚊子无关,就是高烧无汗的麻黄汤症,患者平常吹空调睡眠,堵了淋巴汗腺,夏天该出汗时不出汗,用麻黄汤原方退不了烧 (桂枝9克、麻黄5克、杏仁8克、炙甘草3克),要加大开表的力度有效,麻黄汤去掉炙甘草,加10克细辛、桂枝加大到15克,麻黄调整为12克 ,登革热患者便汗出热退。
散会后,我告诉贺院长,我手头上有两种中药冲剂,防治一切瘟疫,一种叫神农大叶茶,一次3克冲服,只要是高烧无汗都能40分钟内汗出热退,是民间中医梁医生的祖传秘方。另外一种七十二地煞解毒散,是民间中医周老研发的,在治疗毒蛇咬伤的药方上改良配制出来 ,“非典”期间,治疗过三例“非典”患者,都是7天内退烧康复,一次8克,每天一次,开水冲服,连药粉一起内服,患者家属每天也冲服8克,同吃同住都不会感染“非典”,这两种药,肯定能治埃博拉。
当年贺院长听了不以为然,后来我上央视华人频道接受访谈,他才开始注意听。近年来我反反复复地讲禽流感与鸡、白鸽无关,埃博拉与黑猩猩无关,“非典”与果子狸无关,登革热与蚊子无关,但贺院只同意登革热与蚊子无关,其他的半信半疑。这一次主动联系我还是心中不踏实,“你要多带两个民间高手,不能开国际玩笑啊”,我告诉贺院长“神农大叶茶,七十二地煞解毒散,在高温环境下,也能退烧,同时杀灭埃博拉病毒。但不用这两种药,也能治,只是疗效慢很多,同时要离开高温环境,刚发病3天内的患者,将患者转移到森林里,用山泉水泡脚,同时服用当地的退烧药,患者也会汗出热退,转危为安。如果体内有炎症,会反复发烧,需要转移到空调房里,气温20摄氏度以下,病毒会杀灭,患者也就是普通的发烧,发烧13天后,皮肤出血溃烂化脓的患者,开始难治,用神农大叶茶,七十二地煞解毒散,部分人有希望,发烧18天后的患者,五脏出血,神智昏迷的,神仙也难救。”
贺院长听完恍然大悟,连忙将我2017年发表的 《伤寒经方治疗时令瘟疫的心悟》这篇文章转发给姚会长,让他告诉刚果总统埃博拉的来龙去脉,同时和世卫组织的官员沟通,转述中医对埃博拉的防治理念。5月26日,贺院长说他出差,姚会长会派人来拿药,27日下午带去刚果,贺院长的助理会联系我拿药。
埃博拉就是时令瘟疫,每年的5月10日,立夏后出现第一例病患,秋分后开始减弱,到立冬这个节令,完全消失,搞清楚埃博拉的病源,以后防治也就胸有成竹了。只要将患者转移到空调房里,埃博拉病毒就无法存活,冷空气是它的克星。
(本文作者系易道医学研究会会长李庭坤 文章摘引自2018年8月出版的《健康大视野》。)

链接:
2018年埃博拉疫情
(信息摘引自百度百科)
2018年5月23日,刚果(金)卫生部说,随着4个新增确诊病例,本轮埃博拉疫情已确诊21人感染埃博拉病毒,疫区死亡人数升至26人。另外,还有21人被诊断为“很可能”感染埃博拉病毒,4人属于“可能”感染。
2018年7月24日,世界卫生组织宣布,刚果(金)暴发的埃博拉疫情正式结束,但同时呼吁继续努力以应对仍在该国肆虐的其他疾病。世卫组织数据显示,刚果(金)此次共报告53例埃博拉出血热病例,其中29例死亡,6月12日后未再发现新增确诊病例。
欧盟2014年始投2.8亿欧元研究埃博拉奥巴马曾呼吁国会拨款
据新加坡《联合早报》2014年报道,欧盟和制药公司与2014年11月6日宣布,将斥资2.8亿欧元作为埃博拉病毒的研究经费,其中大部分经费将用在加速疫苗的测试与生产。时任美国总统奥巴马也于5日要求国会拨款61.8亿美元,用于控制西非的埃博拉疫情,并同时提高美国本土的应对能力。
据报道,欧盟委员会指派的研究专员莫达斯说:“欧盟决心为埃博拉疫情寻找解决方案。我们将兑现承诺,再拨出2.8亿欧元作为埃博拉病毒的研究经费。”除了欧盟宣布拨出研发经费外,全球各地也有越来越多资金投入。